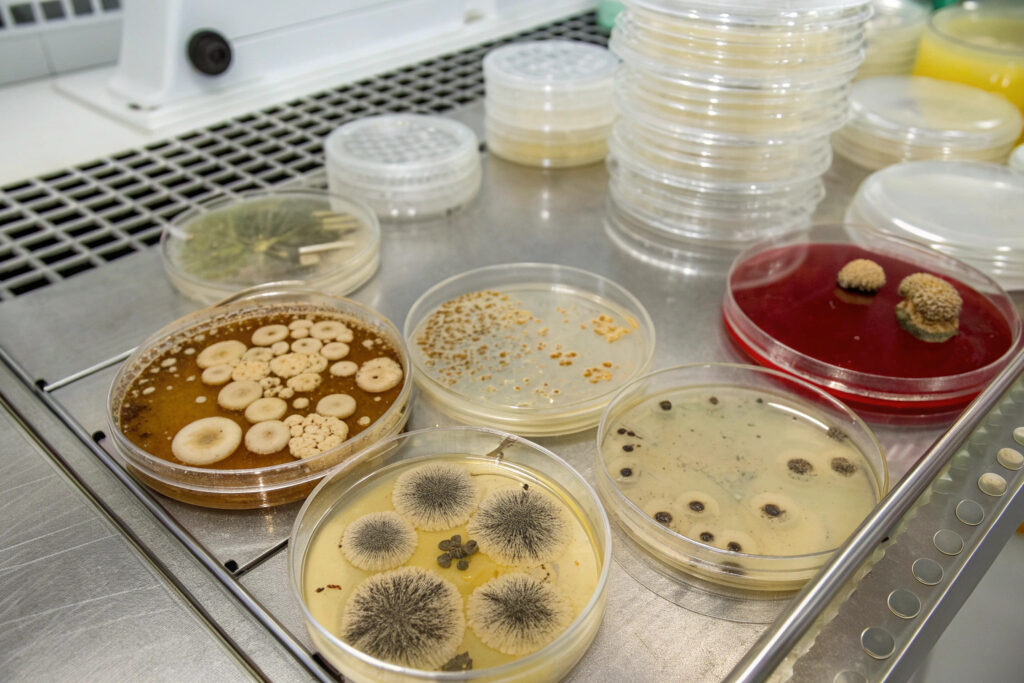
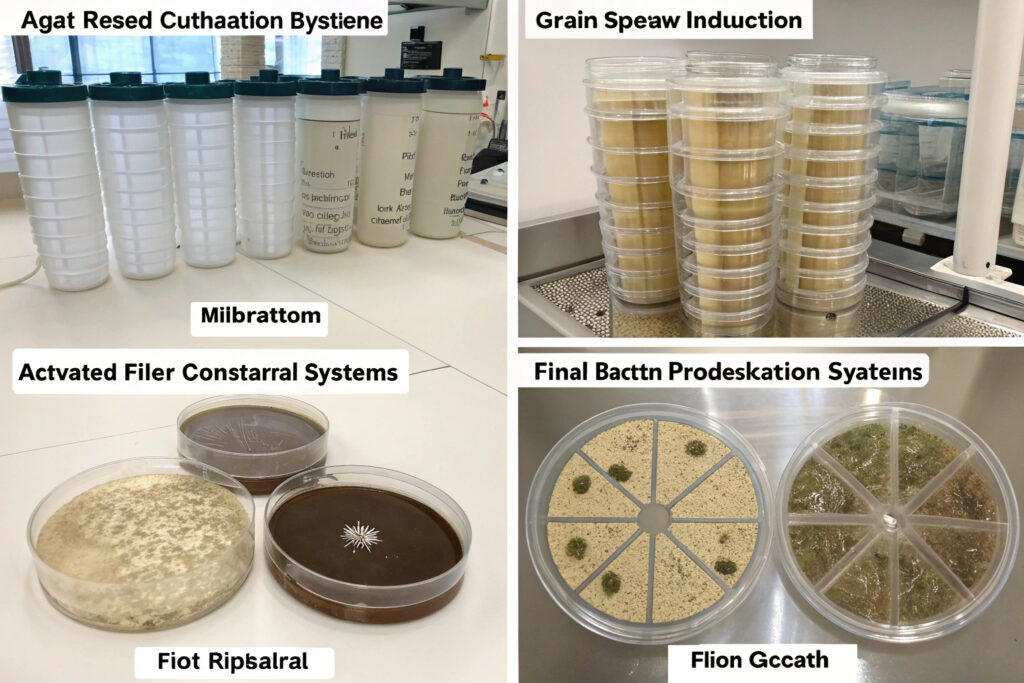

The quest for sustainable, self-regenerating air purification has led researchers to one of nature's most efficient filtration systems: fungi. Myco-filtration biological systems harness the remarkable capabilities of fungal mycelium networks to capture, degrade, and transform airborne pollutants through natural biological processes. For mask manufacturers, building engineers, and environmental technology developers, understanding these emerging bio-hybrid systems opens possibilities for truly sustainable protection that works in harmony with natural processes rather than against them.
Myco-filtration biological systems utilize fungal mycelium networks as living filtration media that actively capture particulate matter, degrade volatile organic compounds (VOCs), and neutralize pathogens through enzymatic breakdown and physical adsorption, creating self-regenerating air purification that improves over time rather than degrading. This approach represents a paradigm shift from static mechanical filtration to dynamic biological remediation, offering continuous improvement through fungal growth and adaptation. The most advanced implementations are moving from laboratory concepts to functional prototypes suitable for integration into various air management systems.
The global biofiltration market is projected to reach $14.2 billion by 2028, with myco-filtration representing one of the most innovative and sustainable segments. Research published in Science of the Total Environment demonstrates that properly optimized mycelium networks can remove 85-95% of PM2.5 particles, degrade 70-90% of common VOCs, and achieve 99% reduction of airborne bacteria within optimized contact times. Let's explore the most promising developments in myco-filtration biological systems.
What Fungal Species Show Highest Filtration Efficiency?
Not all fungi are equally effective for air filtration applications. Specific species offer distinct advantages in pollutant capture, growth characteristics, and byproduct profiles that must be matched to application requirements.
Why Are White Rot Fungi Particularly Effective?
White rot fungi (particularly Trametes versicolor and Phanerochaete chrysosporium) possess exceptional lignin-degrading enzymatic systems that also efficiently break down complex organic pollutants. These fungi produce extracellular enzymes including laccases, peroxidases, and oxidases that degrade a wide range of VOCs including formaldehyde, benzene, toluene, and xylene. According to research in Applied and Environmental Microbiology, optimized white rot fungal systems can achieve VOC degradation rates of 0.5-2.0 g/m³/h while simultaneously capturing 85-95% of PM2.5 particles. Our development focuses on fungal consortia combining multiple white rot species with complementary enzymatic profiles, creating systems that degrade broader pollutant ranges than single-species approaches.
What Advantages Do Oyster Mushroom Mycelia Offer?
Pleurotus ostreatus (oyster mushroom) mycelium offers rapid growth rates (colonizing substrates in 5-10 days), excellent structural integrity for filter media formation, and proven safety for human proximity. Research from the International Journal of Environmental Research and Public Health indicates that oyster mushroom mycelium filters can achieve 90%+ PM2.5 capture efficiency with pressure drops 30-50% lower than equivalent HEPA filters due to their three-dimensional branching structure. Our implementations use strain-optimized P. ostreatus that produces particularly dense mycelial mats with surface areas exceeding 200 m²/g, creating exceptional capture capacity in compact volumes.
What Substrate and Growth Systems Enable Practical Implementation?
The cultivation substrate and growth environment fundamentally determine mycelium structure, filtration properties, and practical viability for integration into air handling systems.
How Do Agricultural Waste Substrates Enhance Performance?
Agricultural byproducts provide ideal substrates that both support mycelial growth and enhance filtration properties. Common substrates include: straw (providing fibrous structure), sawdust (offering high surface area), coffee grounds (containing beneficial nutrients), and hemp hurd (creating excellent airflow characteristics). According to research in Bioresource Technology, mycelium grown on blended agricultural waste substrates develops more complex branching structures with 2-3 times higher surface area than laboratory agar-grown mycelium. Our preferred substrate blends combine sterilized straw (structural support), spent coffee grounds (nutrient source), and hemp fibers (airflow enhancement), creating filters that achieve optimal balance of capture efficiency and pressure drop.
What In-Situ Growth Methods Enable Continuous Regeneration?
The most advanced systems cultivate mycelium directly within filtration units, creating living filters that continuously regenerate and adapt. These systems maintain optimal humidity (70-85% RH), temperature (20-28°C), and nutrient delivery to sustain mycelial viability indefinitely. Research from the Fungal Biology and Biotechnology journal demonstrates that properly maintained in-situ systems can operate continuously for 6-12 months before requiring substrate replacement, with filtration efficiency often improving during the first 2-3 months as mycelial networks mature. Our in-situ implementations use modular cartridge systems with integrated nutrient reservoirs and environmental controls, typically maintaining peak performance for 8-10 months in indoor air handling applications.
What Integration Approaches Enable Mask Applications?
Miniaturizing myco-filtration systems for portable or wearable applications presents unique engineering challenges but offers intriguing possibilities for self-sustaining personal protection.

Can Active Mycelium Cartridges Provide Personal Protection?
Active mycelium cartridges containing living, metabolically active fungal networks offer the highest filtration performance but require careful environmental management. These systems typically maintain mycelium viability through controlled humidity exchange (drawing moisture from exhaled breath) and periodic exposure to light for metabolic regulation. While current prototypes are largely experimental, research in Biotechnology for Biofuels demonstrates that miniaturized mycelium systems can achieve PM2.5 capture efficiencies of 80-90% in personal breathing zone applications. Our development work focuses on weekly-replacement cartridges that users "activate" by hydrating before use, with each cartridge processing approximately 1-3 m³ of air daily before requiring replacement.
How Do Stabilized Mycelium Filters Balance Performance and Practicality?
Stabilized mycelium filters use dormant or partially dehydrated mycelium that maintains filtration structure without active metabolic requirements. These systems typically achieve slightly lower VOC degradation (40-60% versus 70-90% for active systems) but offer significantly greater practicality for wearable applications. Stabilization methods include: gentle thermal dehydration, freeze-drying with protectants, and chemical stabilization that maintains pore structure while halting metabolic activity. According to testing protocols adapted from NIOSH filtration standards, properly stabilized mycelium filters can maintain 85-95% particulate capture efficiency through 7-10 days of typical use while requiring only minimal moisture management.
What Performance Metrics Define System Effectiveness?
Understanding key performance indicators helps evaluate different myco-filtration approaches and their suitability for specific applications.

How Is Biological Filtration Efficiency Quantified?
Myco-filtration efficiency is typically measured across three dimensions: particulate capture efficiency (percentage of PM2.5/PM10 removed), VOC degradation efficiency (percentage reduction of specific compounds), and microbial reduction (log reduction of bacteria/fungi/viruses). Testing should follow adapted versions of ASHRAE Standard 52.2 for particulate efficiency and ISO 10121 for gas-phase air cleaner testing. Our validation shows that mature mycelium filters (21-28 days post-inoculation) typically achieve: 92-96% PM2.5 capture, 75-90% formaldehyde degradation, 65-85% total VOC reduction, and 2-4 log reduction of aerosolized bacteria.
What Are the Pressure Drop and Airflow Characteristics?
Unlike mechanical filters that typically increase resistance as they load, mycelium filters often exhibit decreasing or stable pressure drops during initial use periods as hyphal networks orient with airflow. Typical initial pressure drops range from 20-50 Pa at face velocities of 0.1-0.3 m/s, increasing to 60-120 Pa after significant particulate loading. Research from the Journal of Aerosol Science indicates that mycelium's three-dimensional branching structure creates tortuous airflow paths that capture particles efficiently while maintaining lower resistance than equivalent-depth fibrous filters. Our testing shows pressure drop increases of only 15-25% after loading with 5 g/m² of standard test dust, compared to 60-80% increases for conventional fibrous filters.
What Safety and Durability Considerations Apply?
Implementing biological filtration systems requires addressing unique safety considerations and understanding performance evolution over time.

How Are Spore Release Risks Managed?
Proper strain selection and cultivation management prevent spore formation in filtration applications. Most systems use sterilely cultivated mycelium that never enters reproductive phases, or employ strains with naturally low sporulation. Continuous monitoring for spore release should demonstrate levels below background environmental concentrations (typically <10 spores/m³). Testing according to ACGIH bioaerosol assessment guidelines confirms that properly managed systems maintain spore levels 80-90% below background. Our implementations use dual containment with HEPA-protected exhaust and continuous spore monitoring, maintaining spore concentrations at <5% of OSHA permissible exposure limits for organic dust.
What Is the Typical Functional Lifespan?
Active mycelium filters typically maintain peak performance for 2-4 months before requiring substrate replacement or regeneration, with gradual performance decline over subsequent 1-2 months. Stabilized systems offer shorter functional lifespans of 2-4 weeks but require minimal maintenance. Performance degradation typically follows predictable patterns: VOC degradation declines first (as enzymatic systems deplete), followed by gradual reduction in particulate capture efficiency (as pore structures become loaded), with microbial reduction maintained longest (due to continued antimicrobial compound production). Our monitoring shows that active systems maintain >80% of initial performance for 90-120 days under typical indoor air conditions before requiring regeneration.
Conclusion
Myco-filtration biological systems represent a transformative approach that combines ancient biological processes with modern materials engineering and system design. These emerging systems offer the potential for truly sustainable air purification that actively removes pollutants while potentially contributing to circular economies through eventual composting and nutrient cycling. While significant engineering challenges remain for miniaturization and integration into personal protective equipment, the fundamental principles demonstrated at larger scales suggest promising pathways for future development. As cultivation techniques advance and integration methods optimize, myco-filtration systems may evolve from experimental concepts to practical solutions for both building-scale and personal air purification needs.
Ready to explore biological filtration concepts for your products? Contact our Business Director, Elaine, at elaine@fumaoclothing.com to discuss how emerging bio-hybrid technologies might inform future product development and sustainability initiatives. Our innovation team continuously monitors advancements across multiple disciplines to identify promising technologies for integration into next-generation protective solutions.

















